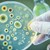
Гъбичните инфекции застрашават все повече хора по света Гъбичните инфекции застрашават все повече хора по света

Доц. Олиана Бойкинова: Морбили може да предизвика тежка пневмония
- Редактор: Мирослава Бонева
- Коментари: 0

За тревожно нарастване на случаите на морбили в Европа алармират от Световната здравна организация (СЗО)
Над 30 000 случая са отчетени в 40 от 53-те държави в региона между януари и октомври 2023 г. В сравнение с 941 случая, докладвани през цялата 2022 г., това представлява над 30-кратно увеличение. Забелязва се драстичен скок на случаите през последните месеци и се очаква тази тенденция да продължи, ако не се предприемат спешни мерки в целия регион, отбелязват от СЗО.
Заради увеличаването на заразените с морбили в Румъния, Австрия, Франция и Германия, последния месец личните лекари в Пловдив масово поставят ваксини срещу морбили. Тъй като заболяването е заразно и лесно разпространимо, доц. Олиана Бойкинова - ръководител на Клиниката по инфекциозни болести към УМБАЛ „Св. Георги” в Пловдив коментира пред вестник Марица.
- Доц. Бойкинова, какво представлява болестта морбили и доколко е реална опасността от появата ѝ в България?
- Морбили (брустница ) е ваксинопредотвратимо заболяване, но поради наличието на неимунизирани възниква възможност за разпространението му. До този момент в България няма установен случай на морбили. Риск от разпространение обаче винаги има, особено при наличието в съседни страни и бързото разпространение по въздушно-капков път. Например през 2017 г. бяха регистрирани 165 случая за страната.
- Как се разпространява болестта?
- Заболяването се причинява от вирус и протича с подчертана периодичност, включваща последователно катарален синдром и макуло-папулозен конфлуиращ обрив. Основно разпространяването на вируса става при кихане и кашляне, когато се отделят капчици от респираторни секрети, съдържащи вируса.
- Има ли възрастова група, която морбили засяга по-често от останалите?
- Възприемчивостта е всеобща, боледуват неимунни лица от всички възрасти, включително новородени.
- Какви са симптомите на морбили?
- Клиничните симптоми се изявяват след скрит период от 9-14 дни и започват с катарални прояви, конюнктивит и кашлица с продължителност от 3 до 5 дни. Налице е обилна слузна секреция от горните дихателни пътища, суха кашлица и повишена температура, която може да достигне до 39-40°С. В края на този период в устната кухина могат да се открият малки бели петънца, т.нар. петна на Филатов - Коплик.
Обикновено обривният период започва между третия и петия ден от началото, с ново повишение на температурата и появата на обрив, който в началото е петнист, но много бързо става надигнат - макулопапулозен. Започва от главата и шията и зад ушите. В следващите дни се разпространява по цялото тяло и накрая - по крайниците. След 5 до 7 дни от появата обривните единици започват да завяхват, като на тяхното място се появява кафеникава пигментация за 7-12 дни. Често се наблюдава дребно трицевидно лющене на кожата.
- Какви могат да са последствията от заразяването с морбили и животозастрашаваща ли е болестта?
- Възможни са леки, средно тежки, тежки и атипични клинични форми.
При тежка форма на заболяване, още в катаралния стадий, може да се развие пневмония, известна като гигантоклетъчна пневмония, която при имунокомпрометирани болни може да бъде животозастрашаваща. Други често срещани усложнения са от страна на дихателните пътища - среден отитит, ларингит, ларинготрахеит. Обикновено през обривния период се развиват вторични бактериални пневмонии. При очите може да се появи кератит и кератоконюнктивит. От страна на ЦНС усложненията са редки, но с изключително сериозна прогноза, като морбилен енцефалит например, който се развива обикновено в края на обривния период. Той протича тежко, с промени в съзнанието, гърчове, значителни остатъчни явления и висок леталитет.
В общи линии прогнозата на заболяването е благоприятна, с изключение на случаите, протичащи с неврологични усложнения и тежка първична пневмония.
Как може да бъде предотвратено заразяване с морбили?
- Специфично лечение няма. Случаите, неусложнени с бактериална инфекция, се лекуват симптоматично - антипиретици, рехидратация, витамини, предимно витамин А и витамин С, изопринозин. При наличие на вторична бактериална инфекция се включват антибиотици. Трябва обаче да се знае, че единствената ефективна профилактика е приложението на живата противоморбилна ваксина (триваксина), която се поставя след навършване на 13 месеца, а на 12 години се извършва реимунизация.
- Поема ли се лечението на морбили от Здравната каса?
- При хоспитализирани пациенти лечението се поема от Здравноосигурителната каса.
Доц. Олиана Бойкинова е завършила с отличие ВМИ-Пловдив през 1983 г. През целия си професионален път работи като инфекционист. От 1985 г. практикува в Клиниката по инфекциозни болести и клинична паразитология към УМБАЛ „Св. Георги“ - Пловдив, както и към Катедрата по инфекциозни болести, паразитология и тропическа медицина на МУ- Пловдив. През 1989 г. придобива клинична специалност "Инфекциозни болести". Защитава дисертационен труд на тема „Клинични и епидемиологични проучвания на острата хепатит С вирусна инфекция сред рискови групи”. През 2008 г. става доктор по медицина, а през 2017 г. придобива научно звание "доцент".
От 2003 г. до 2013 г. е началник на отделението по общи инфекции към клиниката. От април 2020 г. е ръководител на Катедрата по инфекциозни болести, паразитология и тропическа медицина в Медицински университет - Пловдив., от ноември същата година и досега е началник на Клиниката по инфекциозни болести и клинична паразитология към УМБАЛ „Св. Георги“ в Пловдив.